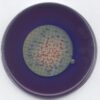

Linalool for synthesis 5ml Merck
0 ₫
Linalool for synthesis. Code: 8186270005. Là hóa chất dùng trong tổng hợp, xây dựng khối hữu cơ trong phòng thí nghiệm. Được sử dụng như một chất trung gian hóa học. Quy cách: Chai thủy tinh 5ml.
| Tên sản phẩm: | Linalool for synthesis |
| Tên khác: | 3,7-Dimethyl-1,6-octadien-3-ol |
| CTHH: | C₁₀H₁₈O |
| Code: | 8186270005 |
| Hàm lượng: | ≥ 97.0 % |
| Hãng – Xuất xứ: | Merck – Đức |
| Ứng dụng: |
– Là hóa chất dùng trong tổng hợp, xây dựng khối hữu cơ trong phòng thí nghiệm. – Được sử dụng như một chất trung gian hóa học |
| Tính chất: |
– Hình thể: lỏng, không màu – Khối lượng mol: 154.25 g/mol – Mật độ: 0,86 g/cm3 (20 °C) – Giới hạn nổ: 0,9 – 5,2% (V) – Điểm chớp cháy: 79 °C – Nhiệt độ đánh lửa: 235 °C – Giá trị pH: 4,5 (1,45 g/l, H₂O, 25 °C) – Áp suất hơi: 0,10 hPa (20 °C) – Độ hòa tan: 1,45 g/l |
| Bảo quản: | Nhiệt độ lưu trữ dưới +30°C. |
| Quy cách: | Chai thủy tinh 5ml |
Sản phẩm tham khảo:
| Code | Quy cách |
| 8186270005 | Chai thủy tinh 5ml |
| 8186270250 | Chai thủy tinh 250ml |
Hãy là người đầu tiên nhận xét “Linalool for synthesis 5ml Merck” Hủy
Sản phẩm tương tự
Hóa chất thí nghiệm
Hóa chất thí nghiệm
CAL Check™ Chuẩn Sắt Thang Thấp, 0.00 và 0.80 mg/L HI96746-11 Hanna
Hóa chất thí nghiệm
CAL Check™ Chuẩn Mangan Thang Thấp, 0 và 150 μg/L HI96748-11 Hanna
Hóa chất thí nghiệm
Dung dịch hiệu chuẩn Natri 2.3 g/l chai 500 mL HI7080L Hanna
Hóa chất thí nghiệm
Titriplex® III solution for 1000 ml, c(Na₂-EDTA 2 H₂O) = 0.01 mol/l Titrisol®
Hóa chất thí nghiệm
Potassium iodate solution for 1000 ml, c(KIO₃) = 1/₆₀ mol/l (0.1 N) Titrisol®
Hóa chất thí nghiệm
CAL Check™ Chuẩn Màu Trong Nước, 0 và 250 PCU HI96727-11 Hanna
Hóa chất thí nghiệm

Đánh giá
Chưa có đánh giá nào.